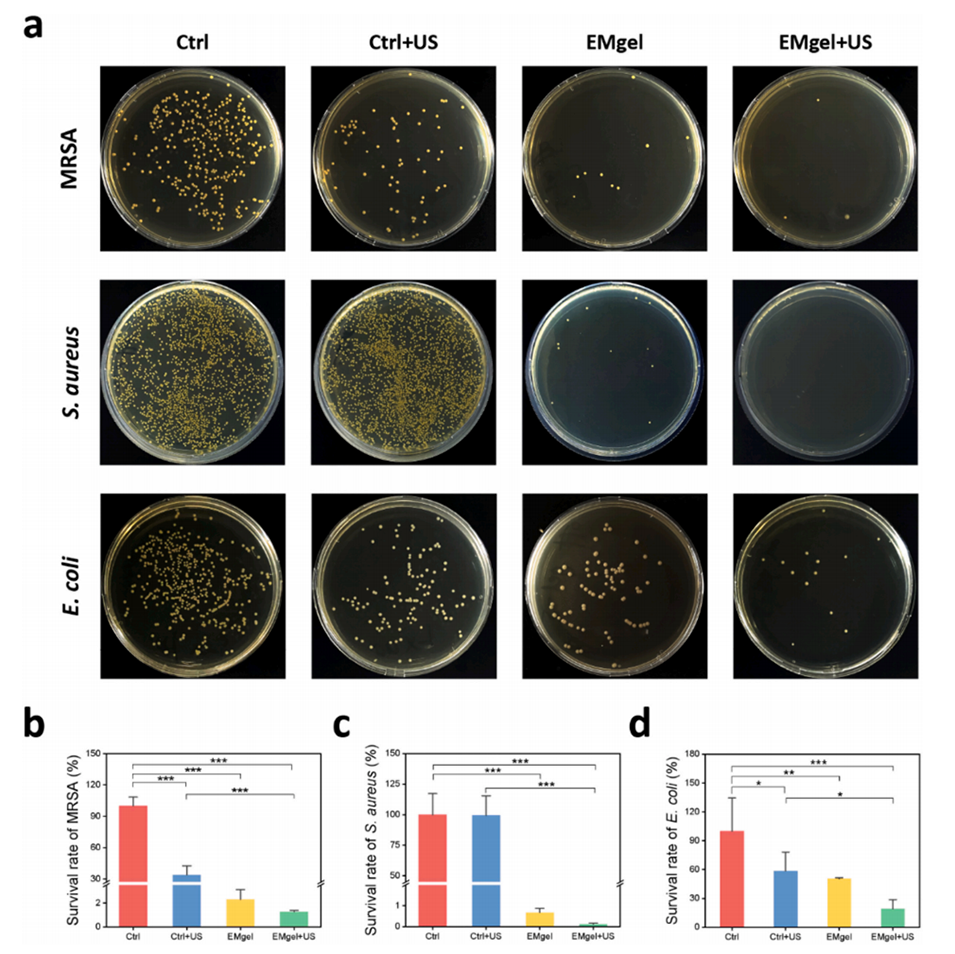

细菌感染诱导的生物膜和骨组织缺损严重阻碍了慢性骨髓炎的治疗。打破致密而顽固的生物膜至关重要,这样目标药物才能更有效地输送到受感染的骨骼。

近期,南方医科大学第三附属医院王平团队联合广东省科学院生物与医学工程研究所曾志文团队,采用微流控技术设计并制备了一种可注射、声学响应型多功能水凝胶微球(EMgel),用于通过超声波破坏生物膜并释放内部封装的生物活性物质,以促进耐甲氧西林金黄色葡萄球菌(MRSA)感染慢性骨髓炎的骨再生。相关研究以“Injectable hydrogel microsphere-bomb for MRSA-infected chronic osteomyelitis”为题目发表于期刊《Journal of Controlled Release》。
本文要点:
1、本研究开发了一种声学响应型多功能水凝胶微球“炸弹”(EMgel),用于治疗MRSA感染的慢性骨髓炎。
2、通过微流控技术制备的EMgel可注射至骨感染病灶,然后在穿透性超声作用下爆破,破坏细菌生物膜屏障,释放封装的天然多酚EGCG和生物活性MoS2以修复受损骨骼。
3、实验结果表明,EMgel具有控制药物释放、良好的抗菌性(高达99%)、高生物膜抗性、优异的抗氧化性、细胞相容性和成骨分化能力。
4、免疫组化染色显示EMgel+超声组表现出最低的炎症反应和最高的成骨标志物OCN表达。
5、该研究提出了一种基于水凝胶微球的智能药物递送新设计,用于治疗骨髓炎,在慢性骨感染、药物递送系统和组织工程方面显示出巨大的潜力。
本研究制备的声学响应型多功能水凝胶微球(EMgel)主要包含以下关键组成部分:
1、甲基丙烯酸酯化透明质酸(HAMA):作为微球的基质材料,具有良好的生物相容性和可注射性。
2、表没食子儿茶素没食子酸酯(EGCG):一种从绿茶中提取的多酚类化合物,具有抗菌、抗炎和抗氧化特性,被封装在水凝胶微球中用于抗菌治疗。
3、二硫化钼(MoS2)纳米颗粒:具有促进成骨作用的生物活性物质,被封装在水凝胶微球中以促进受损骨骼的修复。
4、光引发剂(LAP):用于在紫外线照射下促进HAMA的光交联,形成稳定的水凝胶微球结构。
5、超声波:作为外部刺激源,用于触发水凝胶微球的爆破,从而在感染部位释放封装的EGCG和MoS2。
这些组分共同构成了具有声学响应能力的水凝胶微球“炸弹”,用于穿透和破坏细菌生物膜,靶向递送抗菌和促成骨物质,以促进慢性骨髓炎的愈合。
超声爆破EMgel的作用机制如下:
1、声学响应释放:在超声作用下,EMgel微球的结构会发生变化,导致其破裂。这种破裂是由于超声能量转化为热能和机械能,增加了微球内部的压力,最终导致微球的破裂。
2、破坏生物膜:细菌生物膜是细菌群体生存和抵抗抗生素攻击的一种重要形式。超声爆破EMgel可以破坏细菌生物膜的结构,使得细菌失去保护屏障,从而更容易被抗菌剂消灭。
3、药物释放:EMgel微球内封装的EGCG和MoS2在超声爆破下被释放出来。EGCG具有抗菌和抗氧化特性,而MoS2则有助于促进骨组织再生。
4、增强药物穿透性:超声爆破可以增加局部组织的血流和提高药物在组织中的穿透性,使得药物更有效地到达感染部位。
5、促进骨修复:释放的MoS2和其他生物活性因子可以促进骨细胞的增殖和分化,加速骨组织的修复过程。
6、减少炎症反应:超声爆破EMgel的同时,EGCG的释放有助于减少炎症反应,为骨修复创造一个更有利的局部环境。
7、协同效应:超声和EMgel中的活性成分共同作用,可以产生协同效应,提高抗菌效率并促进骨修复的效果。
总的来说,超声爆破EMgel的作用机制是通过外部超声刺激触发微球的破裂,释放封装的生物活性物质,破坏细菌生物膜,同时促进药物的穿透和骨组织的修复,从而实现对慢性骨髓炎的有效治疗。

图1.a)EMgel溶液在不同储存温度和不同时间的图像。b)通过微流控芯片制造EMgel的示意图(左)和通过金相显微镜获得的形态(右)。比例尺:50μm。c)EMgel的SEM图像。比例尺:10μm。d)EMgel的粒径分布。e)超声辐照引起EMgel爆破原位诱导药物释放的示意图。插图:EMgel在超声辐照之前(US关闭)和之后(US打开)的SEM图像。比例尺:10μm。f,g)EMgel的EGCG和Mo2+在(US开启)或(US关闭)超声辐照下的释放行为。h,i)有或没有超声辐照的EMgel的频率扫描试验(ω=0.1-628rad/s)。j,k)有或没有超声辐照的EMgel的应变振幅扫描试验(γ=0.01-100%)。
图2.超声波响应型EMgel的抗菌活性。

图3.超声波响应型EMgel的抗生物膜活性。

图4.超声波响应型EMgel的生物相容性和抗氧化性。

图5.超声波响应型EMgel的成骨分化能力。

图6.体内治疗。

图7.超声波响应型EMgel在MRSA感染的慢性骨髓炎SD大鼠中的免疫组织化学分析。
论文链接:https://doi.org/10.1016/j.jconrel.2024.10.021
Previous: 上海大学马立团队:微流控技术制备pH敏感型海藻酸盐水凝胶微囊,用于肠道靶向给药






